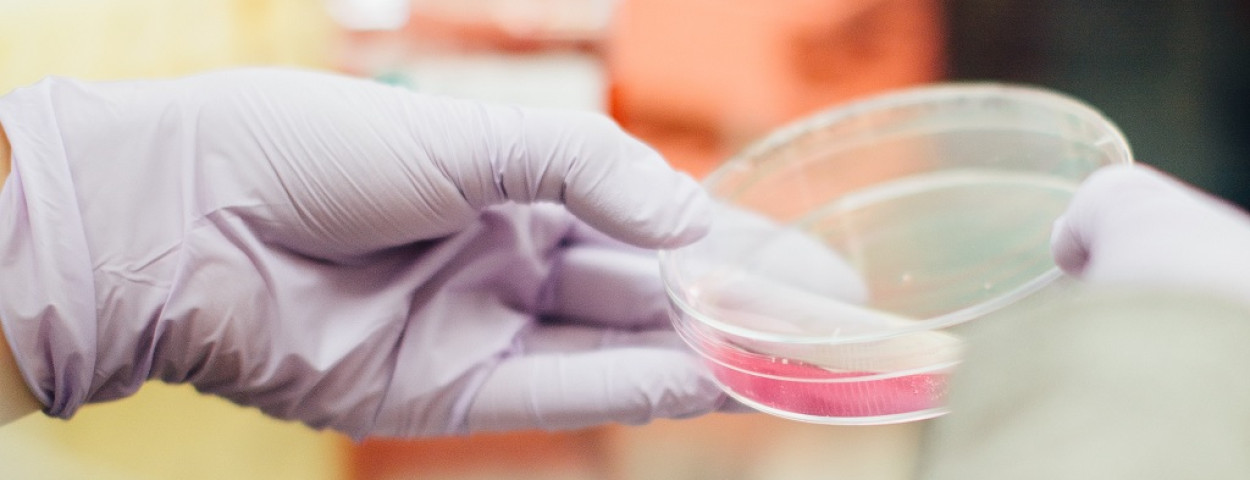

Singapore laat de verkoop van kweekvlees toe
nieuwsEen mijlpaal in de voedingsindustrie, zo wordt de goedkeuring van Singapore genoemd. Kippencellen gekweekt in bioreactoren mogen daar nu officieel verkocht worden. De ‘kipbites’ van Eat Just zullen in eerste instantie enkel beschikbaar zijn in een plaatselijk restaurant.
Kweekvlees, geproduceerd in bioreactoren zonder dat een dier geslacht moeten worden, is voor het eerst goedgekeurd voor verkoop. De ‘kipbites’, geproduceerd door het Amerikaanse bedrijf Eat Just, werden goed bevonden door het Singapore Food Agency. “Hiermee zetten we de eerste stap naar een toekomst waarin we vlees kunnen eten zonder dat we dieren moeten doden”, klinkt het bij Eat Just. Het in 2011 opgerichte bedrijf hoopt met zijn kweekvlees de milieuschade door vleesconsumptie te beperken.
De kippencellen worden gekweekt in een bioreactor van 1200 liter en vervolgens gecombineerd met plantaardige ingrediënten. De kipbites zouden aanzienlijk duurder zijn dan conventionele kip totdat de productie werd opgeschaald. “Maar uiteindelijk zal ons gekweekt vlees goedkoper zijn dan gewoon vlees”, aldus Eat Just.
De cellen die gebruikt werden om het proces te starten, zijn afkomstig uit een celbank. Daarin worden cellen bewaard van biopsieën van levende dieren. Ook bij het winnen van de cellen, kwam er dus geen dood dier aan te pas. De voedingsstoffen die vervolgens aan de groeiende cellen werden toegevoegd, zijn allemaal afkomstig van planten. “Vlees dat in bioreactoren wordt gekweekt, vermijdt ook de problemen van bacteriële besmetting door dierlijk afval en het overmatig gebruik van antibiotica en hormonen bij dieren”, klinkt het nog.
Is het anders? Zeker weten
Al zijn er nog uitdagingen, de reactie van de consument bijvoorbeeld. “Is het anders? Zeker weten”, reageert Josh Tetrick van Eat Just. “We hopen door transparante communicatie de consument voor ons te winnen. Uit voedingstechnisch oogpunt zijn onze kippencellen uit het labo trouwens net hetzelfde als gewone kip.”
Andere uitdagingen zijn het verkrijgen van wettelijke goedkeuringen in andere landen en het opschalen van de productie. "Als we heel Singapore van onze kip willen voorzien en onze markt op termijn verder willen uitbouwen, zullen we naar reactoren van 50.000 liter of meer moeten gaan”, reageert Josh Tetrick.
Eat Just is lang niet het enige bedrijf dat wedt op de verkoop van vlees uit de fabriek. De oprichters van het Nederlandse Mosa Meat haalden zeven jaar geleden de wereldpers met hun gekweekte hamburger. Ondertussen zijn er wereldwijd enkele tientallen bedrijven die de mogelijkheden van kweekvlees onderzoeken.
Piepklein Singapore investeert in eigen voedselproductie
Niet alleen gewone burgers slaan door de coronapandemie massaal aan het hamsteren, ook bij sommige overheden is een soort voedselnationalisme ontstaan. Toen tijdens de eerste coronagolf de grenzen wereldwijd gesloten werden voor zowel reizigers als voor sommige buitenlandse producten, kwam in Singapore een oud zeer bovendrijven: liefst 90 procent van de voedselvoorziening komt uit het buitenland. Dus versnelt de kleine, maar rijke stadstaat een spraakmakend investeringsprogramma dat de lokale voedselproductie - letterlijk - naar grote hoogten moet duwen. Industriële gebouwen worden in sneltempo kweektorens voor verticale stadslandbouw.
Zo kunnen sla, basilicum en de lokale bladgroente choy sum in de beste omstandigheden gestapeld worden in hypermoderne 'groenteflats'. Meer dan een dozijn verticale kweektorens - constructies met op elkaar gestapelde lagen groenten - zagen de voorbije jaren het levenslicht. Volgens de laatste cijfers van de Singapore Food Authority zijn er nu 31. Je vindt ze overal: boven op het dak van een parkeergarage en zelfs midden in een fabriek voor semiconductoren. Door extra te investeren - in kweektorens én in viskwekerijen op zee - wil Singapore tegen 2030 liefst 30 procent van zijn voeding zelf produceren. Nu is dat amper 10 procent.
Bron: The Guardian / De Standaard / Food&Agribusiness